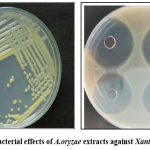

Manuscript accepted on : 01-07-2025
Published online on: 22-08-2025
Plagiarism Check: Yes
Reviewed by: Dr. Ichrak Jaouadi
Second Review by: Dr. Dave Kruti
Final Approval by: Dr. Wagih Ghannam
Mebin John Bosco
and Dheepan George*
Department of Microbiology, AVS College of arts and science (Autonomous), Salem, India.
Corresponding Author E-mail: dheepanmicro2021@gmail.com
ABSTRACT: The goal of the quest for an efficient Aspergillus oryzae bioimmunostimulant was to improve soil fertility and control illnesses in paddy farming. Aspergillus oryzae strains were selected and assessed for their capacity to generate bioactive substances with immunostimulant control in paddy farming using a methodical process. The effectiveness of the bioimmunostimulant in increasing soil fertility and preventing illnesses in rice fields was validated by bioactivity tests. According to the study, bioimmunostimulants promote the growth of beneficial microbial populations, trigger defence mechanisms in plants, and enhance the uptake and use of nutrients, venting illnesses in rice fields was validated using bioactivity tests. Field tests indicated improvements in crop health, nutrient availability, and soil microbial activity while reducing the incidence and severity of paddy diseases.
KEYWORDS: Aspergillus oryzae; Bioactive compounds; Bioimmunostimulant; Crop health; Defense mechanisms; Soil fertility
| Copy the following to cite this article: Bosco M. J, George D. A Comprehensive Study of Aspergillus Oryzae-Derived Bioimmunostimulants for Enhancing Soil Fertility and Managing Diseases in Oryza SativaL. Biotech Res Asia 2025;22(3). |
| Copy the following to cite this URL: Bosco M. J, George D. A Comprehensive Study of Aspergillus Oryzae-Derived Bioimmunostimulants for Enhancing Soil Fertility and Managing Diseases in Oryza SativaL. Biotech Res Asia 2025;22(3). |
Introduction
Aspergillus oryzae is a filamentous fungus, which has an ability to secrete large amounts of hydrolytic enzymes.1 Endophytes are powerful biostimulants in inhibiting pathogens, enhancing environmental stress tolerance through an antioxidant system and promoting plant growth, nutrient availability and yield of the crop through the production of indole acetic acid, siderophore, volatile compounds, inorganic phosphate solubilisation.2 Soil fertility is crucial for agricultural productivity, affecting plant growth, nutrient uptake, and crop yield. Maintaining soil fertility is essential for intensive cropping systems like paddy cultivation. Bioimmunostimulants, substances that stimulate plant defense mechanisms, are derived from plants, microbes, and microbial fermentation products. Aspergillus oryzae, is a notable source due to its rich metabolic diversity and immunostimulatory properties. It is known for its immunomodulatory compounds, has the potential to stimulate plant defense responses, improve nutrient uptake efficiency, and suppress soil-borne pathogens.3 This bioimmunostimulant producer could offer cost-effective solutions for smallholder farmers in resource-limited regions. The plant’s diverse biological activities, including antimicrobial, antioxidant, and immune stimulatory properties, make it a valuable candidate for biocontrol and plant growth promotion.4 The development of effective bioimmunostimulant formulations could also provide cost-effective solutions for smallholder farmers in resource- limited regions.
The exploration of Aspergillus oryzae-derived bioimmunostimulants holds particular promise for enhancing soil fertility and disease management in paddy cultivation. By stimulating plant defense mechanisms and modulating soil microbial communities, these bioactive compounds can improve crop resilience to biotic and abiotic stresses while enhancing nutrient uptake and soil structure.5
Unlike synthetic agrochemicals, which may have adverse effects on human health and the environment, bioimmunostimulants derived from natural sources offer a safer and more environmentally friendly alternative for crop protection and enhancement.6 Aspergillus oryzae-derived bioimmunostimulants are a viable option for paddy cultivation’s Integrated Pest Management (IPM) techniques. These bioactive substances can lessen the need for chemical pesticides by strengthening plants’ natural defenses. This will minimize pollution in the environment and slow the spread of pesticide resistance in insect populations.7
The development of bioimmunostimulants from Aspergillus oryzae has the potential to improve soil health and nutrient cycling in paddy fields. These bioactive compounds promote beneficial soil microorganisms and enhance nutrient uptake efficiency in crop plants, contributing to soil restoration and sustainable agricultural landscape management8. This study aimed to isolate Aspergillus oryzae from the source material, identify it through molecular analysis, extract metabolic compounds, prepare bioformulation for field study, and measure the vigour index of paddy in pot culture under greenhouse conditions.
Materials and Methods
Preparation of Sabouraud Dextrose Agar (SDA) Plates
Prepare SDA according to the manufacturer’s instructions using a standard recipe. The molten SDA was poured into sterile Petri dishes to form a uniform layer, ensuring that bubbles were not produced.
Inoculation of Aspergillus oryzae
A source of Aspergillus oryzae spores contaminated material was obtained. The surface of the agar medium was lightly scraped to dislodge spores. A cotton swab was used to softly swab the surface of the material. The inoculum was streaked onto the surface of the SDA plates using a inoculating needle.9
Incubation
Seal Petri dishes with parafilm to prevent contamination. Incubate the inoculated SDA plates at 25-30°C, the optimal temperature for Aspergillus oryzae growth. Regularly check the plates to determine if any fungal growth has appeared. Depending on the initial spore concentration and developmental conditions, colonies usually emerge within 3–7 days.10
Isolation of Pure Cultures
Once fungal colonies appeared on the SDA plates, individual colonies that appeared morphologically similar to Aspergillus oryzae were selected for further isolation. Using a inoculation needle, streak the selected colonies onto fresh SDA plates to obtain isolated colonies. The streaking process was repeated until pure cultures of Aspergillus oryzae were obtained, characterized by uniform morphology and growth characteristics.11
Storage of Isolated Cultures
To maintain isolated cultures for future use, a portion of the pure culture was transferred to fresh SDA plates and incubated until growth was observed. After growth was observed, the plates were covered and kept for just a few days at 4°C.12
Isolation of Fungal DNA
The standard TRIZOL method was successful in RNA isolation from filamentous fungi when combined with CTAB. Using this process, fungal mycelia’s cell walls are broken down by grinding in a pre-chilled mortar and pestle with liquid nitrogen. Mycelia powder was homogenised in 0.75 mL CTAB lysis buffer (100 mM Tris-HCl (pH 7.5), 5 M NaCl, 0.5 mM EDTA, 1% CTAB, and 1% PVP). Before extraction, 1% β-mercaptoethanol was added to the CTAB buffer. The mixture was then incubated in a water bath at 65°C for 10 minutes and gently mixed.After adding an equivalent amount of acid phenol (pH: 4.5) to the mixture, vortex it vigorously for 5 seconds before centrifuging it at 13,000 rpm for 10 minutes at 4°C. The supernatant was extracted twice with an equal amount of phenol/chloroform (24:1). The tubes were shaken briskly for 1-2 minutes, then chilled on ice for 10 min before centrifugation at 13,000 × g for 15 min at 4°C. During this phase separation procedure, the mixtures were divided into three phases: upper-aqueous, middle-interphase, and lower- phenol-chloroform.To precipitate the RNA, a clear aqueous phase was transferred into a 1.5 ml new eppendorf vial with the addition of 1/3rd volume of 8 M LiCl and 300 µl of chilled ethanol and incubated overnight at -20°C. The next day, the mixture was centrifuged at 10, 000 rpm for 15 min. The resulting RNA pellet was washed with 75% ethanol, air-dried, and dissolved in 50 µL RNase-free water.13
PCR Amplification
The reagents were added in the appropriate order to a microcentrifuge tubes. It is beneficial to set up a master mix without the template and aliquot it into reaction tubes for a large number of reactions. Finally, the tubes were filled with the template. Gently mix by vortexing and then quickly centrifuge to gather all the ingredients at the bottom of the tube. If a thermal cycler was used without a heated lid, 50 µL of mineral oil was added to the top of each tube to stop the evaporation. The primers and heat cycler employed affect the amplification parameters. System optimization for each primer, template, and heat cycler is required. After ethidium bromide labelling, agarose gel electrophoresis was used to assess the amplified DNA.14
Gel Electrophoresis
Analyze the PCR products by running them on an agarose gel to confirm successful amplification. Add Agarose (0.4 g) in TAE buffer (50 ml) and heat until it melts. Pour the molten gel (at 55°C) in a gel casting platform with a comb on one end inserted and allow it to spread and solidify. Once the gel solidified, the cover was removed, the comb was removed, and the gel was placed in an electrophoresis tank with enough electrophoresis buffer to cover the gel by approximately 1 mm. Using a micropipette, 2–5 µL of DNA (100 µL) was loaded into each well after adding 5 µL of ethidium bromide and 2 µL of Bromophenol Blue (loading buffer). The electrophoresis system at 50V till the bromophenol blue dye reached the bottom of the gel. To observe the DNA bands, the power source was turned off and the gel was set under UV light.15
Sequencing
The PCR products were sequenced by Sanger sequencing to determine the DNA sequence of the amplified region. Analyze the DNA sequence using MEGA12 software to compare it with reference sequences in databases such as NCBI GenBank. Confirm the identity of Aspergillus oryzae based on sequence similarity and phylogenetic analysis.16
Extraction of bio active compound from A.oryzae
Inoculate Aspergillus oryzae spores onto suitable growth medium (Sabouraud Dextrose Broth) in a sterile flask. Incubate the culture under optimal conditions for fungal growth. Allow Aspergillus oryzae to grow for a specific period (5-7 days) until the culture reaches the desired growth phase and metabolite production. Harvest the fungal culture by filtering it through filter paper or membrane filters to separate the mycelium from the liquid culture medium. Collect the mycelium biomass for further processing. Transfer the collected mycelium biomass into a ethanol solvent to extract the intracellular metabolites. Agitate the mixture to facilitate the extraction process and enhance metabolite recovery. Repeat the extraction process with fresh solvent to improve the extraction efficiency. Concentrate the extracted solution using a rotary evaporator to remove the solvent and obtain a crude extract containing metabolic compounds. Filter the crude extract to remove any particulate matter or debris.17
Vigour index of A.oryzae extracts with paddy
To calculate the vigor index for paddy (rice) seeds in pots(6.5”×5”inches). Fill planting pots with potting soil and vermiculite, leaving space at the top for watering. Sow paddy seeds evenly across the surface of the soil in each pot. Aim for a consistent seeding density. Gently water the pots to moisten the soil. Overwatering was avoided because excess moisture can lead to seed rot or fungal diseases. Place the pots in a greenhouse with optimal temperature of 25°-30° C and lighting conditions for rice seed germination and growth. Ensure that the environment remains consistently moist but is not waterlogged throughout the germination and seedling growth periods. The pots were monitored regularly for seed germination and seedling growth. The number of days it takes for the seeds to germinate and the emergence of seedlings. The length of each seedling from the base of the seed to the tip of the longest leaf was measured with a ruler.18
Calculating Vigor Index: After a predetermined period (e.g., 7 days), calculate the vigor index using the following formula:
Vigor Index = (Seedling Length in cm) x (Number of Germinated Seeds)
Multiply the average seedling length by the total number of germinated seeds in each pot.
Results
Isolation of A. oryzae
The solid-phase cultivation of Aspergillus oryzae strain on SDA media revealed significant differences in their growth and development. At the first stage of growth (24 h), we observed swelling and germination of spores, as well as the formation of hyphae in the culture. At the second stage (42 hours), the culture displayed a somewhat slower rate of growth and mycelium development along with the release of metabolites and additional warmth (the medium layer temperature rose to 34°C) (Fig:1).
Table 1: Morphology of Aspergillus Oryzae
| Morphology | A.oryzae |
| Hyphae | Septate, hyaline |
| Conidiophores | Smooth-walled |
| Conidia | Smooth-walled, chains |
Colony Morphology
Colonies appear white at first, turning yellow-green as they mature.
Texture: Cottony to powdery with radial growth.
Reverse side of the colony: Pale yellow to brown.
![]() |
Figure 1: A.Oryzae in Agar and Broth culture |
![]() |
Figure 2: KoH Staining of A.Oryzae |
![]() |
Figure 3: LPCB Staining of A.Oryzae |
The results based on their pattern of hyphae, conidiophores and conidia of fungus (Fig:2), (Fig:3), (Table:1).
![]() |
Figure 4: PCR products of the ITS region of A. oryzae |
Every isolate’s ITS region was successfully amplified using universal primer pairs (ITS1) to produce PCR products with a size of 616 bp. Bioinformatics analysis, which was carried out by comparing the ITS region’s sequence results with sequence data registered in the NCBI nucleotide BLAST (https://www.ncbi.nlm.nih.gov/nuccore/PV030924), accessed on February 03, 2025, revealed that the ITS identified the species A. oryzae (Fig: 4).
Vigour index with paddy seedlings of A. oryzae
Table 2: Vigour index with paddy seedlings of A. oryzae
| Fungi | Germination % | Shoot length | Root length | Vigour index |
| A.Oryzae | 2.25±0.21 | 3.12±0.43 | 2.82±0.18 | 67.96±5.2 |
The effects of A. oryzae liquid bioformulation on promoting rice development were investigated using a pot experiment in a greenhouse. Growth parameters such fresh weight, root/shoot ratio, number of leaves, metabolites, and root and shoot length and height were tracked in seedlings fed with the A. oryzae liquid formulation. Readings were taken every seven days for up to nine weeks after planting (Table: 2).
Antimicrobial Sensitivity Testing
β-galactosidase is a prominent enzyme present in A. oryzae, and its antimicrobial effects against pathogenic bacteria such as xanthomonas have been studied.
![]() |
Figure 5: Antibacterial effects of A.oryzae extracts against Xanthomonas oryzae |
Zone of inhibition on media plate confirmed that extracts of A.oryzae contain antibacterial effects against bacterial blight pathogen (Fig:5).
Further cultures and its extracts of A.oryzae was taken for the filed evaluation against paddy infections in large scale.
Discussion
This study investigates the efficacy of a bioimmunostimulant derived from A. oryzae in enhancing soil fertility and controlling paddy diseases. By producing hydrolytic enzymes such as cellulases, proteases, and pectinases that break down cell walls or plant tissue, endophytes colonise themselves inside the host plant. The effectiveness of the bioimmunostimulant in enhancing soil fertility is discussed, with a focus on improvements in soil microbial activity, nutrient availability, and overall soil health.19 It also evaluates its efficacy in disease management, particularly against common paddy pathogens, such as Xanthomonas oryzae. Similarly, the production of hydrolytic enzymes like amylases, cellulase, pectinases and gelatinases by A. oryzae is responsible for degrading the hyphal cell wall of phytopathogen.20 The mechanisms of bioimmunostimulants are discussed, including stimulation of beneficial microbial populations, induction of plant defense mechanisms, and enhancement of nutrient uptake and utilization.21 It is also possible that factors other than the bioimmunostimulant might also influence soil microbial activity. Metabolic products produced from fungi have properties of antibacterial, antifungal, antidiabetic, antioxidant, and immunosuppressive. They are proven to inhibit the growth of different pathogenic fungi and bacteria. The performance of bioimmunostimulants needs to be compared with that of conventional chemical fertilizers and pesticides. There are also potential limitations, such as variability in field conditions, that could affect the efficacy of the bioimmunostimulant.22 The practical aspects of applying the bioimmunostimulant are discussed, along with its potential economic and environmental benefits. Further research is needed to enhance the effectiveness and applicability of bioimmunostimulants for paddy cultivation. The study concludes with key findings emphasizeizing the potential of Aspergillus oryzae-derived bioimmunostimulants for sustainable agriculture and future food security.
Conclusion
In conclusion, the results of the vigour index demonstrate the potential use of bioimmunostimulants generated from Aspergillus oryzae in sustainable paddy farming. Bioimmunostimulants offer an environmentally friendly alternative to conventional chemical fertilizers and pesticides, contributing to soil fertility enhancement and disease management while promoting sustainable agricultural practices. Antimicrobial Sensitivity Testing revealed a better zone of inhibition against blight bacteria. Further research is warranted to optimize the formulation, application methods, and dosage of bioimmunostimulants for their practical use in paddy fields. Overall, the development and adoption of Aspergillus oryzae-derived bioimmunostimulants have the potential to revolutionize paddy cultivation practices, improve crop productivity, and ensure long-term agricultural sustainability.
Acknowledgement
We thank TNSCST Government of Tamilnadu for instrumentation facilities provided to the Department of Microbiology, AVS College of Arts and Science (Autonomous), Salem. We also thank Dr. I. Carmel Mercy Priya, Principal, Dr. S. S. Maithili, Vice-Principal and Thiru. K. Rajavinayakam, Secretary AVS College of Arts and Science (Autonomous), Salem.
Funding Sources
The author received no financial support for the research, authorship, and publication of this article.
Conflict of Interest
The authors do not have any conflict of interest.
Data Availability Statement
This statement does not apply to this article.
Ethics Statement
This research did not involve human participants, animal subjects, or any material that requires ethical approval.
Informed Consent Statement
This study did not involve human participants, and therefore, informed consent was not required.
Clinical Trial Registration
This research does not involve any clinical trials.
Authors’ Contribution
J. (Mebin John Bosco): Data Collection, Analysis, Writing – Review & Editing.
D. (Dheepan George): Methodology, Writing – Original Draft, Visualization, Supervision, Project Administration.
References
- Abe, Keietsu, Gomi, Katusya, Hasegawa, Fumihiko, Machida, Masayuki. Impact of Aspergillus oryzae genomics on industrial production of metabolites. Mycopathologia. 2006;162(3):143-153. doi:https://doi.org/10.1007/s11046-006-0049-2
CrossRef - Dubey, Anamika, Malla, Muneer Ahmad, Kumar, Ashwani, Dayanandan, Selvadurai, Khan, Mohammad Latif. Plants endophytes: unveiling hidden agenda for bioprospecting toward sustainable agriculture. Critical Reviews in Biotechnology. 2020;40(8):1210-1231. doi:https://doi.org/10.1080/07388551.2020.1808584
CrossRef - Han, Haiyan, Yu, Chunyan, Qi, Jianzhao, Wang, Pengchao, Zhao, Peipei, Gong, Wenbing, Xie, Chunliang, Xia, Xuekui, Liu, Chengwei. High-efficient production of mushroom polyketide compounds in a platform host Aspergillus oryzae. Microbial Cell Factories. 2023;22(1). doi:https://doi.org/10.1186/s12934-023-02071-9
CrossRef - Tatsimo, Simplice Joel Ndendoung, Tamokou, Jean de Dieu, Havyarimana, Léopold, Csupor, Dezső, Forgo, Peter, Hohmann, Judit, Kuiate, Jules-Roger, Tane, Pierre. Antimicrobial and antioxidant activity of kaempferol rhamnoside derivatives from Bryophyllum pinnatum. BMC Research Notes. 2012;5(1). doi:https://doi.org/10.1186/1756-0500-5-158
CrossRef - Fajaruddin, undefined, Karmiati, undefined, Aulya, Wanda, Fitriani, undefined, Persada, Andri Yusman. The effect of silica liquid fertilizer from straw and formulation of bacillus sp for rice growth (Oryza sativa L.) and tolerance to fungi Pyricularia oryzae Cav. IOP Conference Series: Materials Science and Engineering. 2020;725(1):012067. doi:https://doi.org/10.1088/1757-899x/725/1/012067
CrossRef - Liu, Meixin, Wang, Yuanhong. S1P receptor 1 antagonist ponesimod alleviates postherpetic neuralgia in rats by normalizing spinal TRPV1 expression and inhibiting MAPK-mediated glial activation.. Cytotechnology. 2025;77(4):141. doi:https://doi.org/10.1007/s11157-019-09500-5.pdf
CrossRef - Siah, Ali, Magnin-Robert, Maryline, Randoux, Béatrice, Choma, Caroline, Rivière, Céline, Halama, Patrice, Reignault, Philippe. Natural Agents Inducing Plant Resistance Against Pests and Diseases. Sustainable Development and Biodiversity. 2018;:121-159. doi:https://doi.org/10.1007/978-3-319-67045-4_6
CrossRef - Han, Haiyan, Yu, Chunyan, Qi, Jianzhao, Wang, Pengchao, Zhao, Peipei, Gong, Wenbing, Xie, Chunliang, Xia, Xuekui, Liu, Chengwei. High-efficient production of mushroom polyketide compounds in a platform host Aspergillus oryzae. Microbial Cell Factories. 2023;22(1). doi:https://doi.org/10.1186/s12934-023-02071-9
CrossRef - Suleiman, Waleed Bakry. A multi-aspect analysis of two analogous aspergillus spp. belonging to section Flavi: aspergillus flavus and aspergillus oryzae. BMC Microbiology. 2023;23(1). doi:https://doi.org/10.1186/s12866-023-02813-0
CrossRef - Balakrishnan, M., Jeevarathinam, G., Kumar, S. Kiran Santhosh, Muniraj, Iniyakumar, Uthandi, Sivakumar. Optimization and scale-up of α-amylase production by Aspergillus oryzae using solid-state fermentation of edible oil cakes. BMC Biotechnology. 2021;21(1). doi:https://doi.org/10.1186/ s12896-021-00686-7
CrossRef - Han, Haiyan, Yu, Chunyan, Qi, Jianzhao, Wang, Pengchao, Zhao, Peipei, Gong, Wenbing, Xie, Chunliang, Xia, Xuekui, Liu, Chengwei. High-efficient production of mushroom polyketide compounds in a platform host Aspergillus oryzae. Microbial Cell Factories. 2023;22(1). doi:https://doi.org/10.1186/s12934-023-02071-9
CrossRef - Uwineza, C., Sar, T., Mahboubi, A., & Taherzadeh, M. J. (2021). Evaluation of the cultivation of Aspergillus oryzae on organic waste-derived vfa effluents and its potential application as alternative sustainable nutrient source for animal feed. Sustainability, 13(22), 12489. https://doi.org/10.3390/ su132212489.
CrossRef - Schumann, Ulrike, Smith, Neil A, Wang, Ming-Bo. A fast and efficient method for preparation of high-quality RNA from fungal mycelia. BMC Research Notes. 2013;6(1). doi:https://doi.org/10.1186/ 1756-0500-6-71
CrossRef - Kramer, Martha F., Coen, Donald M.. Enzymatic Amplification of DNA by PCR: Standard Procedures and Optimization. Current Protocols in Molecular Biology. 2001;56(1). doi:https://doi.org/10.1002/ 0471142727.mb1501s56
CrossRef - Harbison, Amanda M., Nguyen, Jenny Ngoc Tran. PCR: Identification of Genetic Polymorphisms. Methods in Molecular Biology. 2017;:193-203. doi:https://doi.org/10.1007/978-1-4939-6990-6_13
CrossRef - Suleiman, Waleed Bakry. A multi-aspect analysis of two analogous aspergillus spp. belonging to section Flavi: aspergillus flavus and aspergillus oryzae. BMC Microbiology. 2023;23(1). doi:https://doi.org/10.1186/s12866-023-02813-0
CrossRef - Balakrishnan, M., Jeevarathinam, G., Kumar, S. Kiran Santhosh, Muniraj, Iniyakumar, Uthandi, Sivakumar. Optimization and scale-up of α-amylase production by Aspergillus oryzae using solid-state fermentation of edible oil cakes. BMC Biotechnology. 2021;21(1). doi:https://doi.org/10.1186/s12896-021-00686-7
CrossRef - Yamane, K., Garcia, R., Imayoshi, K., Mabesa‐Telosa, R.C., Banayo, N.P.M.C., Vergara, G., Yamauchi, A., Sta. Cruz, P., Kato, Y.. Seed vigour contributes to yield improvement in dry direct‐seeded rainfed lowland rice. Annals of Applied Biology. 2017;172(1):100-110. doi:https://doi.org/10.1111/aab.12405
CrossRef - Tkaczyk, Miłosz, Nowakowska, Justyna A., Oszako, Tomasz. Plant bio-stimulator fertilizers can be applied in integrated plant management (IPM) in forest nurseries. Folia Forestalia Polonica. 2015;57(4):201-209. doi:https://doi.org/10.1515/ffp-2015- 0020
CrossRef - Liu, Application of Aspergillus Niger in the resourcable utilization of straw. IOP Conference Series: Earth and Environmental Science. 2021;859(1):012092. doi:https://doi.org/10.1088/1755-1315/859/1/012092
CrossRef - Liu, Meixin, Wang, Yuanhong. S1P receptor 1 antagonist ponesimod alleviates postherpetic neuralgia in rats by normalizing spinal TRPV1 expression and inhibiting MAPK-mediated glial activation.. Cytotechnology. 2025;77(4):141. doi:https://doi.org/10.1007/s11104-014-2131-8.pdf
CrossRef - Meena, Dinesh Chand, Birthal, Pratap Singh, Kumara, T. M. Kiran. Biostimulants for sustainable development of agriculture: a bibliometric content analysis. Discover Agriculture. 2025;3(1). doi:https://doi.org/10.1007/s44279-024-00149-5
CrossRef

This work is licensed under a Creative Commons Attribution 4.0 International License.